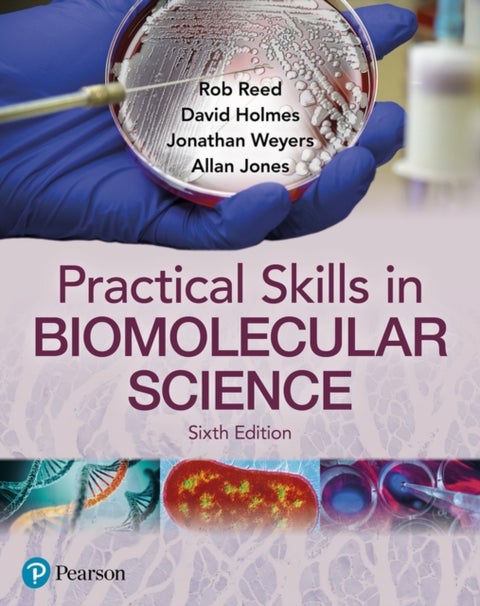
Practical Skills in Biomolecular Science

- Bøker
- Spill og puslespill
- Leker
- Babyleker
- Dukker, bamser og figurer
- Lego
- Uteleker
- Hobby og kreativitet
- Kreative leker
- Lekebiler og togbaner
- Lekebiler og togbaner
- Utkledning og sminke
- Utkledning og sminke
- Småleker og actionleker
- Småleker og actionleker
- Populære merker
- Babyleker
- Sekker og skolesaker
- Skolesekker
- Barnehagesekker
- Gymbag
- Matbokser og drikkeflasker
- Matbokser og drikkeflasker
- Pennaler
- Skolemateriell
- Tilbehør
- Papir og kontor
- Tegne og male
- Gaver, interiør og reise
- Inspirasjon
- Tilbud
- Gavekort
Favoritter
David Holmes
Bøker skrevet av David Holmes
15 resultater
- Cameron Dunn, Kim Adams, David Holmes, Simon Oakes, Sue Warn, Michael Witherick, Michael Chiles429,-Pocket| Engelsk
- Varenummer:
- 9781036011451
- Utgivelsesår:
- 2024
- Rob Reed, David Holmes, Jonathan Weyers, Allan Jones589,-Pocket| Engelsk
- Varenummer:
- 9781292397085
- Utgivelsesår:
- 2021
- David Holmes, Cameron Dunn, Dan Cowling429,-Pocket| Engelsk
- Varenummer:
- 9781382029193
- Utgivelsesår:
- 2023
- Bob Digby, Nicholas Rowles, David Holmes429,-Pocket| Engelsk
- Varenummer:
- 9781382029124
- Utgivelsesår:
- 2022
- David HolmesPearson Edexcel A-level Geography Coursework Workbook: Non-exam assessment: Independent Investigatio129,-Pocket| Engelsk
- Varenummer:
- 9781510468757
- Utgivelsesår:
- 2019
- John Dean, Alan Jones, David Holmes, Rob Reed, Jonathan Weyers, Allan Jones679,-Pocket| Engelsk
- Varenummer:
- 9781292139920
- Utgivelsesår:
- 2017
- Brian Goetz, Tim Peierls, Joshua Bloch, Joseph Bowbeer, David Holmes, Doug Lea589,-Pocket| Engelsk
- Varenummer:
- 9780321349606
- Utgivelsesår:
- 2006